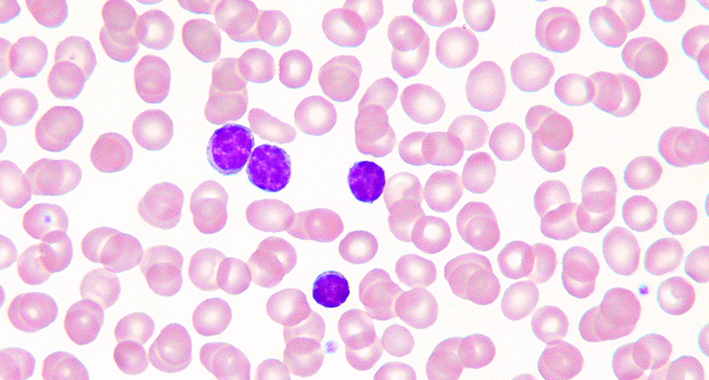

Premio Nobel de Medicina 2025 por «Descubrimientos sobre la tolerancia inmune periférica”.
🏅 Ganadores
- Mary E. Brunkow (EE. UU.)
- Fred (Frederick) J. Ramsdell (EE. UU.)
- Shimon Sakaguchi (Japón)
🔬 ¿Qué descubrieron?
- El sistema inmunológico es muy poderoso, pero necesita mecanismos de regulación para evitar atacar los propios tejidos del cuerpo. (NobelPrize.org)
- Estos científicos identificaron las células T reguladoras (“regulatory T cells” o T regs), que actúan como “guardianes del sistema inmunológico”, asegurando que las células del sistema inmune no ataquen el propio organismo. (NobelPrize.org)
- En 1995, Sakaguchi descubrió esta clase de células, mostrando que hay un mecanismo adicional al que se conocía (la tolerancia central en el timo) para evitar autoinmunidad. (NobelPrize.org)
- En 2001, Brunkow y Ramsdell encontraron que la mutación en el gen Foxp3 causa desregulación inmune, lo que conecta la función de T regs con un gen específico. (NobelPrize.org)
- Luego, Sakaguchi demostró que el gen Foxp3 regula el desarrollo y la función de estas células reguladoras. (NobelPrize.org)
📈 Importancia y aplicaciones
- Este descubrimiento explica por qué no todos desarrollamos enfermedades autoinmunes, a pesar de tener sistemas inmunitarios potentes.
- Abre caminos para terapias inmunológicas: potenciar o modular las células T reguladoras podría servir para tratar enfermedades autoinmunes, mejorar los trasplantes, o incluso optimizar terapias contra el cáncer. (
- Algunas de estas ideas ya están siendo evaluadas en ensayos clínicos. (NobelPrize.org)
El Premio Nobel de Medicina o Fisiología 2025 fue otorgado a Mary E. Brunkow, Fred Ramsdell y Shimon Sakaguchi por sus avances en la comprensión de la tolerancia inmunológica periférica, un proceso esencial del sistema inmunitario que evita que el cuerpo reaccione contra sus propios tejidos.
Este hallazgo fue decisivo para entender cómo el organismo mantiene su equilibrio interno y cómo se originan las enfermedades autoinmunes cuando ese mecanismo falla.
La Asamblea Nobel del Instituto Karolinska de Estocolmo destacó que estos descubrimientos sentaron las bases para el desarrollo de nuevas terapias destinadas a modular la respuesta inmune, con aplicaciones que van desde el tratamiento de la artritis reumatoide hasta la mejora de los trasplantes.
¿Qué es la tolerancia inmunológica periférica?
-
- Es un mecanismo del sistema inmunológico que evita que el cuerpo ataque a sus propios tejidos.
- También impide, según algunos de los textos científicos de referencia de la inmunología a nivel mundial (como Janeway’s Immunobiology), que el cuerpo reaccione de una forma excesiva a algunos antígenos que no son, en principio, especialmente peligrosos y que actúan en la periferia del organismo.
¿En qué se diferencian la tolerancia central de la tolerancia periférica?
-
- El sistema inmunológico aprende a diferenciar entre los organismos propios (los autoantígenos) y los extraños (los patógenos).
- En el interior del cuerpo humano se establece la tolerancia central, que si funciona con normalidad es capaz de eliminar algunos tipos de linfocitos (glóbulos blancos fundamentales en el sistema inmunitario para identificar y combatir patógenos).
Linfocitos sanguíneos. | Wikimedia
Linfocitos sanguíneos. | Wikimedia-
- Pero el sistema inmunológico no es capaz de eliminar todos los linfocitos, ahí es donde cobra importancia la tolerancia periférica, que trata de impedir que aquellos linfocitos que «escaparon» ataquen a los tejidos del propio organismo.
- Esto resulta fundamental para mantener el equilibrio entre la respuesta inmune frente a infecciones y para prevenir enfermedades autoinmunes.
¿Cómo cambiaron estos descubrimientos el entendimiento del sistema inmunológico?
-
- Los galardonados con el Nobel, Brunkow, Ramsdell y Sakaguchi, identificaron las células T reguladoras, actuando como «guardias de seguridad» que monitorean y aseguran que el sistema inmunológico tolere los propios tejidos.
- Sus descubrimientos fueron decisivos para la comprensión de cómo funciona el sistema inmunológico, introduciendo la noción de que el poderoso sistema inmune debe ser regulado (mantenido a raya) para evitar que ataque los propios órganos del cuerpo.
- Los principales cambios en el entendimiento incluyen: que el sistema inmunológico es más complejo de lo que se creía y que requiere de regulación periférica; y que las células T reguladoras previenen que las células inmunes ataquen nuestro propio cuerpo.
 Micrografía electrónica de barrido de glóbulo rojo (izquierda), plaqueta (centro) y linfocito T (derecha); coloreada. | Wikimedia
Micrografía electrónica de barrido de glóbulo rojo (izquierda), plaqueta (centro) y linfocito T (derecha); coloreada. | Wikimedia-
- Las células T reguladoras vigilan a otras células inmunes y aseguran que nuestro sistema inmunológico tolere nuestros propios tejidos. Este mecanismo explica por qué no todas las personas desarrollan enfermedades autoinmunes graves.
¿Qué enfermedad es causada por mutaciones en el gen Foxp3?
-
- Los científicos dieron cuenta del crucial del gen Foxp3, un gen clave que se convirtió en la explicación de por qué una cepa específica de ratón era particularmente vulnerable a las enfermedades autoinmunes.
- Demostrando así que las mutaciones en el equivalente humano de este gen causan una grave enfermedad autoinmune llamada IPEX.
 La dermatitis es uno de los principales síntomas del IPEX. | Wikimedia
La dermatitis es uno de los principales síntomas del IPEX. | Wikimedia- Estos descubrimientos lanzaron el campo de la tolerancia periférica, revelando que existe un mecanismo activo y genéticamente controlado (las células T reguladoras gobernadas por Foxp3) que asegura la autotolerancia fuera del timo (órgano linfoide primario y especializado del sistema inmunitario).
- Esto impulsó el desarrollo de tratamientos médicos para el cáncer y enfermedades autoinmunes, y podría representar avances en el marco de trasplantes más exitosos en el futuro.





















